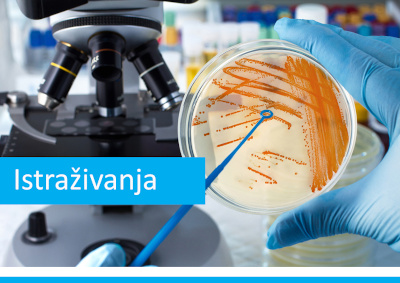

Dobrodošli na stranice Fakulteta prirodnih znanosti!
Fakultet prirodnih znanosti u Puli (FPZ) temelj je razvoja prirodnih i okolišnih znanosti na Sveučilištu. Znanstveni rad naših stručnjaka i suradnika, usmjeren u istraživanja bioraznolikosti i procesa u Jadranu, utjecaja čovjeka na morske ekosustave te pronalaženja novih pristupa u očuvanju i gospodarenju biološkim resursima mora, predstavlja osnovu našeg prijediplomskog sveučilišnog studija Znanost o moru.
Pristupačnost